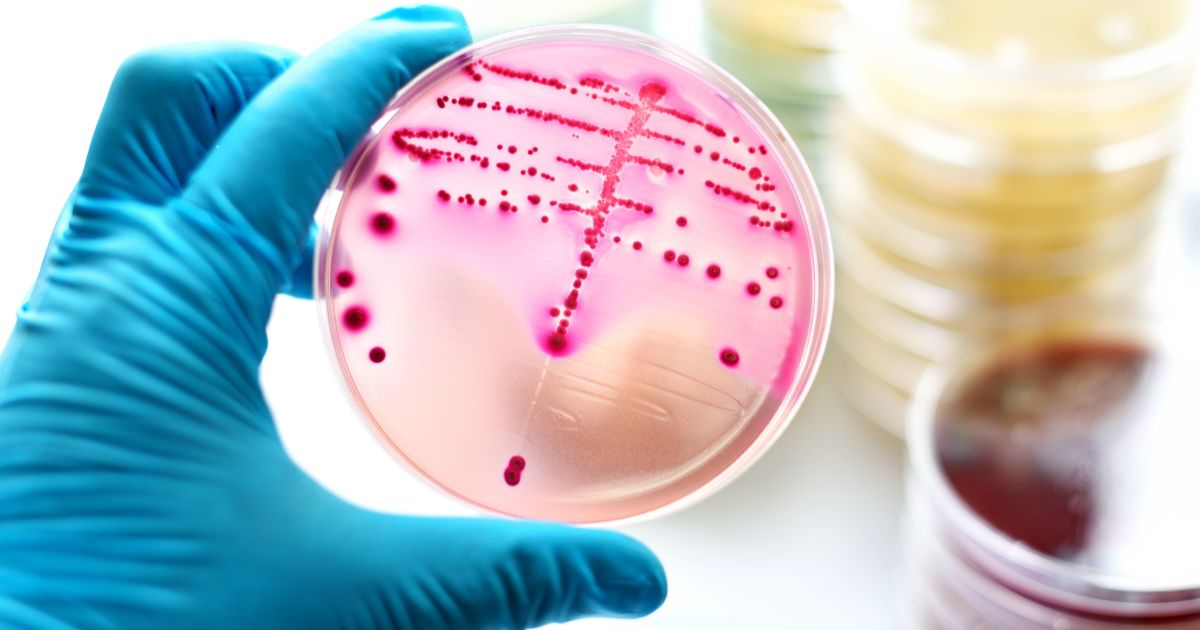
mamaplus

Infecțiile cauzate de aceste microorganisme sunt, de regulă, ușoare. Simptomele care semnalează infecția în organism sunt durerile în gât, febra, erupția cutanată roșie și limba cu aspect de căpșune. Bacteria poate provoca și scarlatina, o boală tratată cu antibiotice, cu recuperare de 100%.
Cu toate acestea, uneori, această bacterie poate pătrunde în sânge, provocând sindromul șocului toxic (SST). Aceasta este afecțiunea care a răpus din septembrie până acum, în Marea Britanie, 10 copii cu vârsta sub 10 ani.
"E adevărat că sunt și cazuri fulminantei – chiar dacă puține, și nu mă refer la scarlatină – care apar în caz de infecție streptococică și aici vorbim despre șocul toxic. Este situația în care apare o infecție generalizată care duce la afectarea importantă a multor organe, o degringoladă la nivelul organismului care poate să ducă, într-un interval scurt, la o evoluție imprevizibilă, chiar și la deces.", spune Dr. Adrian Marinescu, medic primar boli infecțioase, Institutul Matei Balș.
Doctorul spune că această complicație nu apare numai la copii mici. Ea poate să apară indiferent de vârstă, la persoanele cu deficit de sistem imunitar sau cu un sistem imunitar dezechilibrat (boli cronice sau evenimente care le-a slăbit sistemul imunitar).
„Și nu este singura infecție bacteriană care dă astfel de forme fulminante. Dă și meningococul! Deci nu e vorba de scarlatină, ci de mai multe cazuri decât în mod normal de forme fulminante de infecție streptococică“, avertizează medicul infecționist.
Streptococul beta-hemolitic de grup A este o bacterie comună, omniprezentă. Multe persoane sunt purtătoare sănătoase ale acestei bacterii, fără să prezinte simptome. Infecțiile streptococice sunt destul de frecvente. Infecția streptococică nu dă doar scarlatina. Sunt multe infecții, cu diverse localizări. De cele mai multe ori provoacă forme ușoare, care nu necesită spitalizare.
Se cunosc mai mult de 80 de tipuri de streptococi de grup A, fiecare determinând diverse afecțiuni. Unele dintre cele mai frecvente infecții cauzate de streptococii de grup A includ:
Specialiștii avertizează părinții să fie atenți la simptome precum dureri mari în gât și febră mai mare de 38,5 °C. În creștere, febra poate implica și frisoane, dureri musculare, de cap, uneori stări de greață, dureri abdominale sau chiar vomă (mai ales la copii).
În scarlatină, pot să apară pe piele niște pete roșii, aspre la pipăit. Acestea apar de regulă în zona inghinală și axială și sunt semne clare de scarlatină.
În faringita streptococică, semnele care o anunță implică:
În infecțiile urechii interne:
În infecțiile invazive cu streptococ semnele sunt în funcție de localizare:
Sindromul de șoc toxic este o afecțiune rară, adeseori amenințătoare de viață. SST apare brusc după o infecție și poate afecta rapid diferite organe vitale – plămânii, rinichii și ficatul. Toxinele produse de streptococ sunt cele care determină apariția SST. De obicei inofensive, determinând infecții ușoare, atunci când aceste toxine ajung în sânge determină o reacție imună severă, care progresează rapid. Reacția imună care duce la SST este legată de un deficit de anticorpi împotriva toxinei streptococice sau stafilococice.
Simptomele SST sunt:
Dezvoltarea rapidă a simptomelor este cel mai important indiciu pentru SST.
Deși numărul de cazuri de infecție streptococică în Marea Britanie este în creștere, la noi în țară încă nu au fost semnalate cazuri.
În perioada de izolare din anii trecuți, am făcut cunoștință cu un virus care a ocolit copiii. Știm că bebelușii și copiii mici sunt deosebit de vulnerabili la infecții, în special în primele trei luni de viață, deoarece sistemul lor imunitar este încă în curs de dezvoltare.
Știm că bebelușii născuți în perioada de izolare din 2020-2021 au avut o experiență departe de a fi tipică, fiind în mare măsură protejați de expunerea la viruși și de infecțiile bacteriene ca urmare a distanțării și a celorlalte măsuri. Marea întrebare este dacă această perioadă i-a lăsat mai vulnerabili la infecții acum…
„Copiii născuți în perioada de izolare au avut un prim an de viață foarte privilegiat în ceea ce privește expunerea la infecții“, spune dr. Liz Whittaker, consultant în boli infecțioase și imunologie pediatrice și secretar al Grupului britanic de alergii, imunitate și infecții pediatrice.
„Ceea ce vedem de fapt acum, nu arată că acei bebeluși sunt mai vulnerabili, ci pur și simplu că fac infecții respiratorii precum gripa și VSR mai târziu, când sunt mai puțin vulnerabili și mai puțin probabil să facă forme care necesită spitalizare. Motivul pentru care cifrele par mai mari se datorează pur și simplu faptului că se îmbolnăvesc în același timp cu bebelușii născuți recent“, adaugă dr. Whittaker.
În România și R. Moldova, traversăm un sezon dificil al virozelor de sezon. Locurile de la ATI din spitalele de pediatrie sunt deja ocupate, iar numărul cazurilor care se prezintă zilnic la camera de gardă este dublu față de sezonul trecut. Infecții cu VSR, bronșiolite acute, pneumonii, infecții cu rotavirus, SARS-CoV-2, gripă. 10% din copiii care ajung la spital au nevoie de oxigen pentru a putea respira, spun medicii.
„De acum încolo însă va fi o creștere importantă și e foarte probabil să avem un vârf în care vom avea cazuri de gripă și în martie, probabil și în aprilie. Va fi un sezon de lungă durată, plus situații speciale de care am spus, ceea ce îl va face să fie mai intens decât celelalte sezoane de dinainte de pandemie”, spune Dr. Adrian Marinescu, medic primar boli infecțioase, Institutul Matei Balș